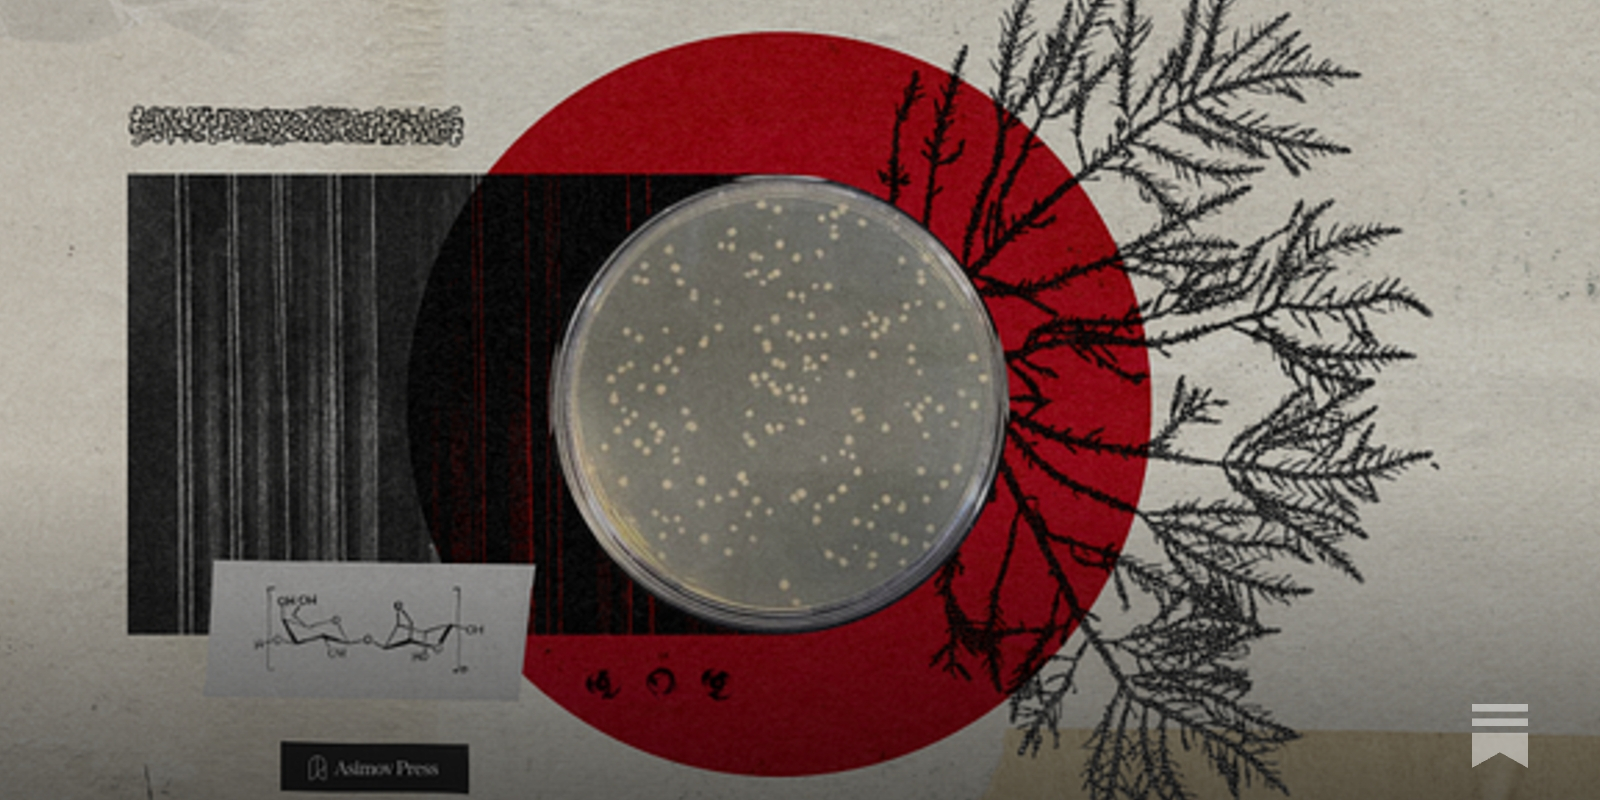

Alpha Portland Cement Company (Defunct), Martins Creek, Pennsylvania
Oh this is nice!
"Journey through the Computer History Museum's vast collection of archival materials, objects, and oral histories and learn about the visionaries, innovations, and untold stories that revolutionized our digital world."
 Computer History Museum opens Virtually.
Computer History Museum opens Virtually.
If your travels take you near Mountain View, California, you can have the pleasure of visiting the Computer History Museum. You can see everything from a PDP-1 to an Altair 8800 to a modern PC there. If you aren’t travelling, the museum has launched a digital portal that expands your ability to enjoy its collection remotely.
https://www.computerhistory.org/collections/catalog
#OpenCHM #computer #history #museum #digital #launch #retrocomputing #retro #tech #media #news
Bidding farewell to the Ironbridge Gorge Museum Trust.
As the site prepares to enter a new era, Ironbridge's collections team reflects on how the pioneering, community-led charity brought the birthplace of the #IndustrialRevolution to life.
https://www.museumsassociation.org/museums-journal/people/2026/02/bidding-farewell-to-the-ironbridge-gorge-museum-trust/# #globalmuseum #museums #history
#Swansea event. #inclusion #history #wales
Those who saw through the false front of fascism and opposed them were beaten, tortured, and killed.
#fascism #uspol #history #propaganda
#Swansea event. #inclusion #history #wales
The Origins of Agar
Those who saw through the false front of fascism and opposed them were beaten, tortured, and killed.
#fascism #uspol #history #propaganda
📣 New Podcast! "27 February 1937: Woolworths sitdown strike" on @Spreaker #history #women #woolworths
https://www.spreaker.com/episode/27-february-1937-woolworths-sitdown-strike--69728392
the more i learn about #Ireland, the more i hate #England, #GreatBritain and the #UnitedKingdom; especially the monarchy.
this documentary on 17th century Irish #slavery needs to be used as a blueprint for what Spain & Portugal did to Muslim and Jewish Iberians. the pogroms, kidnapping and enslavement literally happened until the break of the Spanish-American War.
yes, 1898.
so much #history about internal European colonialism is suppressed, it’s maddening.
Phạm Tuân (who is the first Vietnamese citizen and the first non-Russian Asian in space) is the first Vietnamese to shoot down a B-52 flying a Soviet MiG-2, during LineBacker II (1972, Ha Noi, Viet Nam war)
In 1861 there were 11 Virginian colonels in the US Army, including Robert E Lee. Lee was the ONLY one to join the Confederacy.
In this week's Untitled History pod, Angry Staff Officer and I talk about the Virginians who didn't turn traitor. Including George Thomas, great general. Awesome hat-wearer. #history https://cms.megaphone.fm/channel/the-untitled-history-podcast
My name is Alexandra. I help build I Write Like, a text editor. Unless one is a tech giant, the chances of people discovering their creation are slim, regardless of how wonderful the creation is. I wanted to change that, so I came to Mastodon.
I’m a writer. I share my short stories and poems, often illustrated with my own art and photography. I'm also interested in #science, #history, and #music.
I’m fairly new here and still learning.
Alpha Portland Cement Company (Defunct), Martins Creek, Pennsylvania
Happy Birthday to Jeremy "Jaz" Coleman, lead vocalist of the post-punk group Killing Joke, born on this day in 1960, Cheltenham, UK.
Killing Joke - Love Like Blood (1985 Munich Alabamahalle)
Out of Light Adjust Share: Caravaggio, La Tour, and the Art of Attention
https://harpers.org/archive/2026/03/out-of-light-nicole-krauss-caravaggio-georges-de-la-tour/
#HackerNews #Art #History #Caravaggio #LaTour #Attention #Economy #VisualArts
🖤 For Black History Month, join us in celebrating the first Black classical music composer in France: Joseph Bologne, Chevalier de Saint-Georges.
Inspired by the incredible true story of Bologne in 18th century France, Disney's Chevalier takes place during the lead up to the French Revolution. The film sheds light on the realities of France at this time and can ignite student interest in learning more about the French Revolution as well as this remarkable historical figure.
Our free Chevalier Discussion Guide also explores Bologne's legacy; Beginnings, Opportunity, and Excellence; and Race and Identity. For grades 11-12, adult/higher ed.
🔔 This is also a great film for Music in Our Schools Month in March!
#BlackHistory #BlackHistoryMonth #History #Histodons #BlackVoices #Education #Movies #ClassicalMusic #Music #Homeschooling #Disney #ChevalierDeSaintGeorges #FrenchHistory #WorldHistory #FrenchRevolution
📣 New Podcast! "26 February 1906: Cerbère orange carriers strike" on @Spreaker #france #history #womens
https://www.spreaker.com/episode/26-february-1906-cerbere-orange-carriers-strike--69728383


![[ImageSource: computerhistory.org]
⁉️The portal features advanced search tools along with browsable curated collections and stories. There’s also an album feature so you can create and share your own custom collections. If you are a developer, the portal also allows access via an API.⁉️
👾As an example, I checked out the vintage marketing collection. Inside were a 1955 brochure for a Bendix computer you could lease for under $1,000 a month, and a 1969 brochure for the high-performance Hitachi HITEC 10. It had 4K words of 16-bit memory and a clock just a bit more than 700 kHz, among others.👾
<https://www.computerhistory.org/collections/curator-picks/vintage-marketing-selling-the-future>](https://nerdculture.de/system/media_attachments/files/116/144/052/209/897/795/original/9cf4468c6096abaf.jpeg)